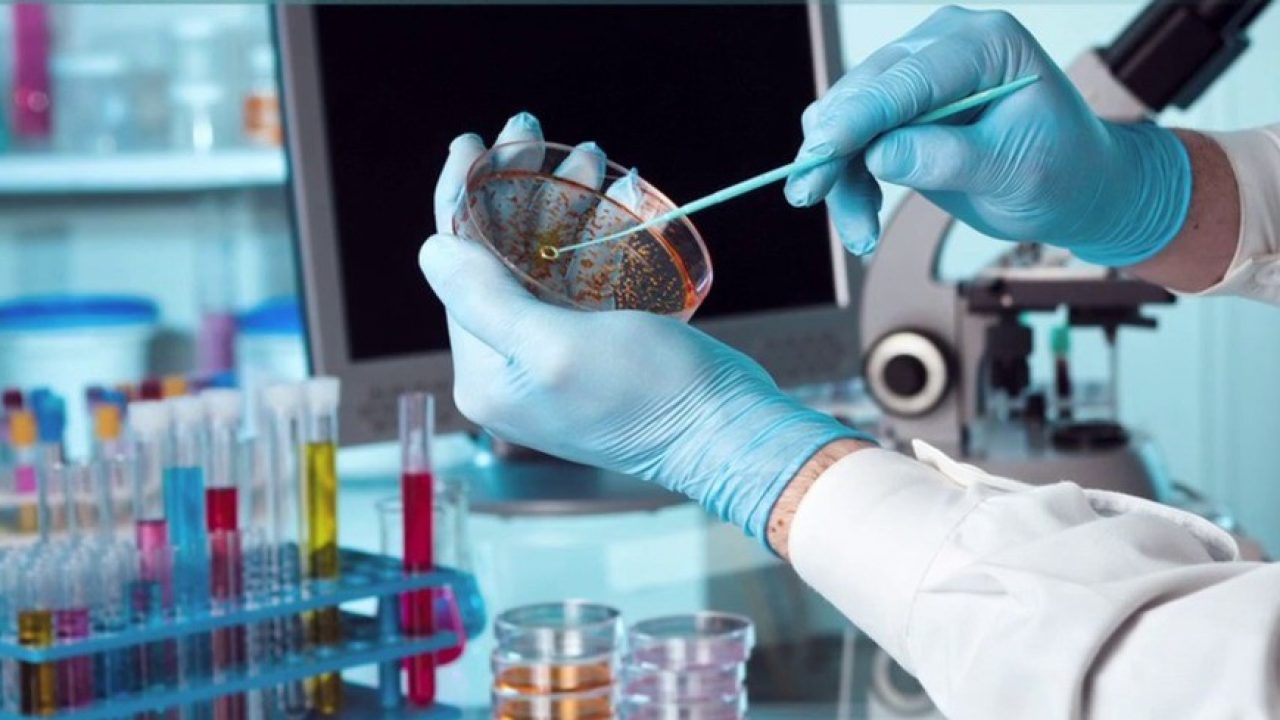

[vc_column_text]OPB Consulting Services Limited is the preferred partner of the world’s biggest and best DNA, Drug and Alcohol Testing Laboratory networks. For close to a decade, our team of Scientists, Analysts and Sample Collectors has collected and analyzed DNA Samples of thousands of donors in Ghana and other West African states for Immigration, Court or Private Peace of Mind determination.[/vc_column_text][vc_text_separator title=”OPB CONSULT” title_align=”separator_align_left”][vc_column_text]OPB Consulting Services is headquartered in Ghana at OTA 26 Gyaase Avenue 1/14, Adum – Kumasi. We can also be located at Ansmerc House, Plot 399, Atomic junction, Accra. With a sample collection network scattered across the length and breadth of the country and beyond. It is our policy to assign all assignments to experienced professionals with proven record in conducting similar assignments.
In partnership with AlphaBiolaboratories and Anglia DNA Services, two of the largest independent United Kingdom Laboratories based in Warrington and Norwich respectively, we offer a wide range of scientific services, specializing in DNA, Drug and Alcohol testing for court-ordered, work-related, immigration and private purposes.[/vc_column_text]
Book An Appointment
Plan your visit to our Laboratory
[vc_empty_space][vc_images_carousel images=”2157,2158,2159,2161″ img_size=”full” slides_per_view=”4″ autoplay=”yes” hide_pagination_control=”yes” wrap=”yes”]
[vc_column_text]
Client Delight
We demonstrate a sense of urgency on any matter related to our clients; we strive to make ourselves easy to do business with; we believe that very satisfied clients are essential for our success.[/vc_column_text]
[vc_column_text]We have followed with keen interest the growing incidents of legal and social tussles with regards to biological relationships (particularly paternity) that may exist between persons of interest. Some of these disputes find their way to institutions such as DOVVSU and recently radio stations. Others ultimately get to seek finality in the relevant law courts of our land.[/vc_column_text][vc_text_separator title=”OUR CORE VALUES” title_align=”separator_align_left”][vc_column_text]
Commitment
We make clearly defined commitments and focus our efforts to meet them.
Integrity
We act with uncompromising ethical standards, both as individuals and as a company
Accountability
We demand personal accountability and timely resolution of problems, regardless of whose job it is.[/vc_column_text]